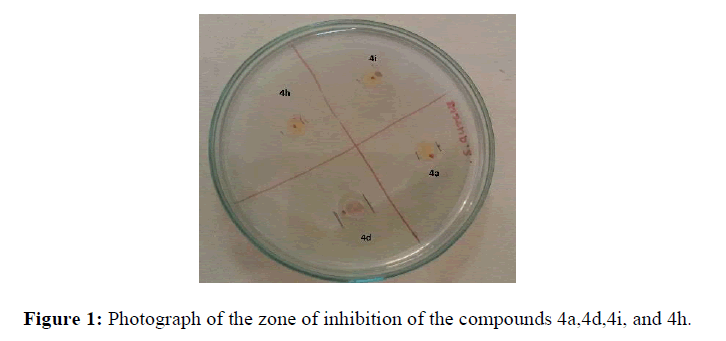

Research Article - Der Pharma Chemica ( 2021) Volume 13, Issue 2
Green Synthesis of Pharmacologically Active Piperazine Substituted Schiff Bases and their Antimicrobial Activities
Krishnakant T Waghmode* and Bandoba T. NikamKrishnakant T Waghmode, Department of Chemistry, D.G. Ruparel College, University of Mumbai, India, Email: krishnakantwaghmode@gmail.com
Received: 01-Feb-2021 Accepted Date: Feb 20, 2021 ; Published: 26-Feb-2021
Abstract
Green synthesis of piperazine substituted Schiff bases is described. Microwave-assisted synthesis not only reduced the reaction time drastically but also gave excellent yields. 2-naphthylpiperazine was converted to its ester followed by hydrazide. Hydrazide of 2-naphthyl piperazine was reacted with various substituted aromatic aldehydes under conventional heating and microwave irradiation method to get the final product. The synthesized compounds are characterized by FT-IR, 1H-NMR, and Mass spectral data.
Keywords
Schiff bases, Microwave irradiations, Piperazine
Introduction
Piperazine is a six-membered heterocyclic compound containing two nitrogen atoms at one and fourth positions respectively. The piperazines are a broad class of organic compounds with a broad spectrum of pharmaceutical properties [1-2]. The literature survey revealed that substituted piperazine derivatives exhibit a wide variety of biological activities. It has been reported that some piperazines demonstrated antibacterial [3], antianginals [4], antidepressants [5], antihistamines [6], antipsychotics [7], Urological activities [8].
Piperazine and its various derivatives show anthelmintic activity, piperazine was first identified as an anthelmintic agent in 1953. Piperazines act generally by paralyzing the parasite which helps the host to expel out the invading organism. This action is mediated by its effect on inhibitory gamma-aminobutyric acid receptors. Piperazine hydrate and piperazine citrate are the main anthelminthic piperazines. These drugs are often mentioned simply as "piperazine" which can cause confusion between the precise anthelmintic drugs and therefore the entire class of piperazine-containing compounds.
2-Naphthyl piperazine and its derivatives show various biological activities. N-[2-(2-naphthyl) ethyl] piperazinyl Quinolones shows antibacterial activity [9]. Optical properties were also found in compounds in which the 4-ethyl piperazine moiety linked the peperone and naphthalene moieties [10]. In vitro binding assays of such a compound against 3H-spiperone revealed a high affinity for dopaminergic D2 receptors. Synthetic procedures for the preparation of a series of piperazine-containing fluorescent compounds have also been described [11]. Some chromones substituted by an aryl alkyl piperazino alkyl side chain are potent and selective sigma ligands and will be interesting within the treatment of psychosis, Synthesis and structure-activity relationships of novel arylalkyl 4-benzyl piperazine derivatives as sigma site-selective ligands have been studied for the treatment of inflammatory diseases [12]. Effects of piperazine derivatives on the activity of frog skeletal muscle fibers have also been studied [13]. Schiff bases form an important class of compounds in medicinal and pharmaceutical chemistry with several biological applications that include antibacterial [14], antifungal [15], and antitumor activity [16].
Microwave-assisted reactions have attracted the great attention of the scientific community because of the rapid, convenient, and efficient method of synthesis of organic compounds [17].
A variety of pharmaceutically important organic compounds are synthesized by the microwave-assisted green synthetic method [18-22].
In this pursuit, and during our studies, we have synthesized Schiff bases substituted piperazine under conventional heating method and microwave irradiation method. Synthesized compounds were studied for their antibacterial activity against one gram-positive and one-gram negative bacteria.
Materials and Methods
All the reagents used in the synthetic reactions were of commercial grade and were used as received without further purification and all solvents were of reagent grade. Microwave-assisted reactions were carried out in a domestic microwave oven (Samsung model). All the reactions were monitored by Thin layer chromatography using 0.25 mm E-Merck silica gel 60 F254 pre-coated glass plates, which were visualized with UV light. Melting points were taken by an open capillary method. The IR spectra were recorded on Perkin-Elmer 257 spectrometers using KBr discs.1H NMR spectra in CDCl3 and DMSO-d6 were recorded on 300 and 200 MHz using TMS as an internal standard.
Typical Experimental Procedures
Procedure for the preparation of Ethyl [4-(2-naphthyl) piperazin-1-yl] acetate [23]
(a) Conventional method using K2CO3: In a round bottom flask, 2-naphthyl piperazine was added in dry DMF solvent, anhydrous potassium carbonate (1.5 molar equiv.), and ethyl chloroacetate (1.0 molar equiv.) were added. The resultant mixture was stirred at 80oC for 10 hours, the completion of the reaction was checked with TLC. The reaction mixture was cooled and then added to a large amount of water. The solid separated was filtered, washed with an excess of water. The crude product was purified by crystallization from ethyl alcohol-water. The yield of the product was 81 %.
(b) Solvent-free microwave irradiation method: A mixture of 2-naphthyl piperazine 1 (0.01 mol), chloroethyl acetate (0.01 mol), and potassium carbonate (0.015 mol) were irradiated in a microwave oven (MW domestic type oven Samsung model) at 300 watts for 12 min. (pulses of 30 seconds each). After completion of the reaction (by TLC), the mixture was poured into ice-cold water. The solid formed was filtered, washed with an excess of cold water, and dried at room temperature.
Procedure for the preparation of Ethyl [4-(2-naphthyl) piperazin-1-yl] acetohydrazides [24]
Ethyl [4-(2-naphthyl) piperazin-1-yl] acetate (0.01 mol) in ethanol (20 cm3) was stirred at room temperature for 20 min. To this mixture hydrazine hydrate (0.015 mol) was added. The resultant mixture was stirred at room temperature for 2 hours, after completion of the reaction (by TLC), the mixture was poured into ice-cold water. The separated solid was filtered, washed with an excess of cold water, and dried at room temperature. The yield of the product was 88 %.
Procedure for the synthesis of 2-[4-(2-naphthyl) piperazin-1-yl]-N-(substituted methylene) acetohydrazides
a) Conventional heating: A mixture of compound 3 (0.01 mol ), aryl / heteroaromatic aldehyde (0.01 mol), and 1 cm3 of glacial acetic acid was taken in methanol and refluxed on a water bath for four hours. The mixture was allowed to cool and poured in ice-cold water then the separated solid was filtered, washed dried, and crystallized with ethyl alcohol.
b) Microwave heating: Compound 3 (0.01 mol) and aryl / heterocyclic aldehyde (0.01 mol), few drops of acetic acid added and mixed well to form a paste. This mixture was irradiated in a microwave oven (MW domestic type oven Samsung model) at 300-watt power (pulses each of 30 sec.), the reaction mixture was irradiated till the competition of the reaction, competition of the reaction was confirmed using TLC, the product was set aside to cool. The separated solid was filtered, washed, dried, and crystallized from ethyl alcohol (Table 1).
Reaction Scheme

Where R=H, -CH3, -NO2, -OCH3, etc.
| Entry | R | Microwaveheating | Conventionalheating | ||
|---|---|---|---|---|---|
| Time (min.) |
Yield % |
Time (hours) |
Yield % |
||
| 4a. | 4-CH3 | 2.5 | 94 | 4 | 80 |
| 4b. | -H | 2 | 92 | 4 | 76 |
| 4c. | 3-NO2 | 4 | 88 | 4 | 65 |
| 4d. | 2-Furyl | 4 | 86 | 4 | 68 |
| 4e. | 4-OCH3 | 2.5 | 90 | 4 | 74 |
| 4f. | 4-OH | 3 | 90 | 4 | 73 |
| 4g. | 2-OH | 2.5 | 91 | 4 | 75 |
| 4h. | 2-Cl | 9 | 89 | 4 | 76 |
| 4i. | 4-N,N(CH3)2 | 3 | 88 | 4 | 72 |
| 4j. | 3-OCH3, 4-OH | 4 | 85 | 4 | 73 |
Table 1: Comparative synthesis of 4a-j under microwave-assisted Vs conventional method of heating in terms of yield and time.
Biological Activity
The antibacterial activity of compounds (4a-4j) was tested for two different bacteria viz. Escherichia coli (E. coli) and Staphylococcus aureus (S. Aureus) Gentamicin was used as a standard drug. The testing was done using the cup-plate technique [25]. DMF was used as a diluent. 10 mg of the sample was diluted to 1 dm3. Sterile molten media was mixed with the culture suspension and two plates for each sample were prepared. Two wells for each plate were bored and 0.1 cm3 of the sample was added to each bore and incubated at 370C for 24/48 Hours. Inhibition zones were observed on the next day. Figure 1 shows the photograph of the zone of inhibition of the compounds 4a,4d,4h, and 4i using the cup-plate technique.
Four compounds were found to be active against the S. Aureus bacteria. The data of which is presented in Table 2.
| Compounds | Zone of inhibition in mm In triplicate | ||
|---|---|---|---|
| I | II | III | |
| 4a. | 9.2 | 9.2 | 9.2 |
| 4d. | 10.4 | 10.4 | 10.4 |
| 4i. | 8.4 | 8.4 | 8.4 |
| 4h. | 8.7 | 8.7 | 8.7 |
| Reference drug-Gentamicin | 16 | 16 | 16 |
Table 2: Antibacterial activities of the compounds
Spectroscopic Characterization Data
4a. N’-(4-methyl benzylidine)-2-[4-(2-naphthyl)piperazin-1-yl]acetohydrazide:
mp.205-2070C; IR(KBr):3479,3247, 3031, 2823, 1681, 1604,1450,1249,1211,1080,817 cm-1, 1H NMR (300MHz, CDCl3): δ 9.98(1H,s,NH), 8.11(1H,s,CH),7.69-7.48(5H,m,Ar-H),7.32-7.37(1H,Ar-H),7.18-7.29(4H,Ar-H),7.15(1H,Ar-H), 3.35-3.33(4H,t), 3.34(2H,S,COCH2N) 2.81-2.85(4H,t,N-(CH2)2), 2.88-2.81(4H,s, N-(CH2)2), 2.32(3H,S,CH3) MS: - m/z=386 (M+)
4b. N’-benzylidine-2-[4-(2-naphthyl)piperazin-1-yl]acetohydrazide:
mp.175-177 0C;IR(KBr):3456, 3055, 2833, 1681, 1581,1450,1388,1249,1218, 1149, 1018, 740, 694 cm-1; 1H NMR(200MHz,DMSO-d6): δ 11.21(,1H,s,NH), 8.31(1H,s,CH),7.74-7.67(4H,m,Ar-H), 7.40-7.26(4H,m,Ar-H) 7.23-7.17(3H,mAr-H), 3.35(4H,t), 3.17(2H,s,), 2.78-2.69 (4H,t). MS:- m/z = 373(M+)
4c. N’-(3-nitrobenzylidine)-2-[4-(2-naphthyl)piperazin-1-yl]acetohydrazide:
mp. 210-120C;IR(KBr):3286,3050,2977,1697,1627,1504,1442,1342,1226,1141,1010, 966,802cm-1; 1H NMR(200MHz,DMSO-d6): δ 11.48(,1H,s,NH), 8.48-8.43(2H,d,Ar-H), 8.20(1H,s,CH),8.07(2H,d,Ar-H),7.9-7.5(6H,m,Ar-H),7.41-7.21(3H,m,Ar-H),7.23-7.15(3H,m,Ar-H), 3.35(4H,t), 3.21(2H,s,), 2.79-2.69 (4H,t). MS:- m/z = 418(M+)
4d. N’-furfurylidine-2-[4-(2-naphthyl)piperazin-1-yl]acetohydrazide:
mp. 170-1720C;IR(KBr):3232,3047,2939,1674,1527,1218,1149,1026, 748 cm-1; 1H NMR(300MHz,DMSO-d6): δ 11.24(,1H,s,NH), 8.30(1H,s), 8.05-6.63(10H,m,Ar-H), 3.58(2H,s,), 3.21-2.76 (8H,m). 3.58(2H, t,CH2), 3.21(2H,s,CH2), 3.21-2.76 (6H,s,(CH2)3-)MS:- m/z = 362(M+)
4e. N’-(4-methoxy benzylidine)-2-[4-(2-naphthyl)piperazin-1-yl]acetohydrazides:
mp.166-1680C; IR(KBr):3440,3178, 3062, 2831, 1681, 1604, 1512, 1249,1072, 748 cm-1, 1H NMR (300 MHz, DMSO-d6): δ 11.11(1H,s,NH), 8.27(1H,s,CH), 7.91-6.99(11H,m,Ar-H), ), 4.04(3H,S), 3.35-3.33(4H,t), 3.20(2H,S) 2.78-2.70(4H,t), 2.32(3H,S) MS: - m/z=402 (M+)
4f. N’-(4-hydroxyoxy benzylidine)-2-[4-(2-naphthyl)piperazin-1-yl]acetohydrazide:
mp.218-2210C; IR(KBr):3440,3093, 2839, 1689, 1604, 1512, 1188,1072, 748 cm-1, 1H NMR (200 MHz, DMSO-d6): δ 11.2(1H,bs,NH), 11.2(1H,bs,OH),8.50(1H,s,CH), 7.73-6.85(11H,m,Ar-H), 3.36-3.33(4H,t), 3.20(2H,S) 2.69(4H,t)
4g. N’-(2-hydroxyoxy enzylidine)-2-[4-(2-naphthyl)piperazin-1-yl]acetohydrazide:
mp. 204-2060C; IR(KBr):3371,3055, 2823, 1681, 1604, 1458, 1149,1080, 748,702 cm-1, 1H NMR (200 MHz, DMSO-d6): δ 11.2(1H,s,NH), 11.2(1H,bs,OH), 8.50(1H,s,CH), 7.73-6.85(11H,m,Ar-H), 3.36-3.33(4H,t), 3.20(2H,S) 2.69(4H,t), MS:- m/z = 389(M+)
4h. N’-(2-Chloro benzylidine)-2-[4-(2-naphthyl)piperazin-1-yl]acetohydrazide:
172-1740C; IR(KBr):3371,3055, 2823, 1681, 1604, 1458, 1149,1080, 748,702 cm-1, 1H NMR (200 MHz, DMSO-d6): δ 11.2(1H,s,NH), 8.50(1H,s,CH), 7.73-6.85(11H,m,Ar-H), 3.36-3.33(4H,t), 3.20(2H,S) 2.69(4H,t)
4i. N’-(4-N,N dimethylbenzylidine)-2-[4-(2-naphthyl)piperazin-1-yl]Acetohydrazide:
mp. 190-1920C ; IR(KBr):3425, 3327,3116, 2977, 1674, 1604, 1527, 1450, 1365, 1257, 1064, 964, 810,740,632 cm-1, 1H NMR (200 MHz, DMSO-d6): δ 10.94(1H,s,NH), 8.14(1H,s,CH), 7.81-6.70(11H,m,Ar-H), 3.36-3.33(4H,t), 3.13(2H,S),2.95( 6H,s), 2.68 (4H,t), MS: - m/z=416 (M+)
4j. N’-(4-hydroxyoxy-3-methoxy benzylidine)-2-[4-(2-naphthyl)piperazin-1-yl] acetohydrazide:
mp. 245-247 0C; IR(KBr): 3325,3178,1674,1589,1512,1388, 1149,1033, 848,748,709,624 cm-1, 1H NMR (200 MHz, DMSO-d6): δ 11.2(1H,s,NH), 8.50(1H,s,CH), 7.73-6.85(10H,m,Ar-H), 3.8(3H,s), 3.36-3.33(4H,t), 3.20(2H,S) 2.69(4H,s), MS: - m/z:- 418 (M+)
Results and Discussions
Synthesis of Ethyl [4-(2-naphthyl) piperazin-1-yl] acetate (compound 2) was carried out by reacting 2-naphthyl piperazine ethyl chloroacetate in presence of K2CO3 as a catalyst under conventional heating as well by using microwave irradiations. The microwave reaction was fast, clean, and energy-efficient. Compound 2 was reacted with hydrazine hydrate in ethanol under reflux condition to give ethyl [4-(2-naphthyl) piperazin-1-yl] acetohydrazide (compound 3). In the next step compound, 3 was reacted with different aromatic aldehydes substituted with electron-donating as electron-withdrawing groups under conventional heating and microwave heating method to get the target compounds, 2-[4-(2-naphthyl) piperazin-1-yl]-N-(substituted methylene) acetohydrazides (compounds 4a-j). The results of the Comparative synthesis of 4a-j under microwave-assisted Vs conventional method of heating in terms of yield and time are given in Table 1. It was observed that aromatic aldehydes substituted with electron-donating or withdrawing groups gave good to excellent yields.
Synthesized compounds were tested for their antibacterial activities against one gram-positive and one gram-negative bacteria. Four compounds were found to be active against the S. Aureus bacteria. Results of antibacterial activities are presented in Table 2.
Conclusion
In conclusion, microwave-assisted synthesis offers several advantages over conventional heating methods such as shorter reaction times, excellent yields, and simple experimental workup procedures. Also, the microwave-assisted solvent-free approach is non-polluting and does not employ any toxic materials quantifying it as a green approach. The mildness of the method together with ease of operation should largely extend the scope of microwave-assisted synthesis which is safe, environmentally friendly, and inexpensive for the synthesis of Schiff bases.
The antibacterial activity of compounds (4a-4j) was tested for two different bacteria viz. E. Coli and S. Aureus. Four compounds (Compounds 4a.,4d., 4i.,4h.) were found to be active against the S. Aureus bacteria.
References
- E Childers, A Wayne, Magid Abou-Gharbia et al., J Med Chem. 2005, 48(10): p. 3467-3470.
- H Zhao, X He, A Thurkauf et al., Bioorg Med Chem Letters, 2002, 12(21): p. 3111-3115.
- AF Brito, LK Moreira, R Menegatti et al., Fundamental Clinical Pharmacology. 2019, 33(1):p. 13-24.
- M Abou-Gharbia, JA Moyer, ST Nielsen et al., J Med Chem., 1995, 38(20):p. 4026-4032.
- JT Tarczewski, GC Helsley, Y Chiang et al., Heteroarylpiperidines, pyrrolidines and piperazines and their use as antipsychotics and analetics. U.S. Patent. 1994,5: p. 364,866.
- BQ Bai, M Yuan, X Zhou. Academic Journal-Guangzhou Medical College. 2007, 35(1): p. 54.
- M Shamsipur, M Ousefi, I Hosseini, et al., Anal Chem. 2001,73: p. 2869.
- A Petric, F Jacobson and JR Barrio. Bioorg Med Chem Lett. 1998, 8: p. 1455-1460.
- JR Barrio and A Patric. Acta Chim Slov. 1998, 45(4): p. 475-486.
- S Younes, S Labssita, Y Baziard-Mouysset et al., Eur J Med Chem. 2000, 35(1): p. 107-21.
- N Radicheva and M Vydevska. General Pharmacology. 1995, 26(6) p. 1431-1439.
- Abu-Hussen. J Coord Chem. 2006, 59: p. 157.
- K Singh, MS Barwa and P Tyagi. Eur J Med Chem. 2006, 41: p. 1.
- R Mladenova, M Ignatova, N Manolova et al., Eur Polym J. 2002, 38: p. 989.
- MS Y Khan and M Akhtar. Ind J Chem. 2003, 42B: p. 900.
- K Singh, MS Barwa and P Tyagi. Eur J Med Chem. 2006, 41:p. 1.
- N Pai, K Waghmode and D Khandekar. Asian J Chem. 2011, 23(12): p. 5217-5219.
- KT Waghmode and PKShinde. Der Pharma Chemica. 2017, 9(22): p. 47-49.
- PD Parmar and KTWaghmode. IOSR J App Chem. (IOSR-JAC). 2017, 10(9): p. 58-60.
- PK Shinde and KT Waghmode. IOSR J App Chem.(IOSR-JAC). 2017, 10(7) p. 86-89.
- KT Waghmode, J. Chem. Pharm. Res., 2014, 6(5): p. 1101-1105.
- KT Waghmode and NR Pai. IOSR J Pharmacy (IOSRPHR). 2012, 2(1): p. 102-105.
- A Hackling, R Ghosh, S Perachon et al., J Med Chem. 2003, 46(18): p.3883-3899.
- N Sinha, S Jain, A Tilekar et al., Bioorg Med Chem letters. 2005,15(6) p. 1573-1576.
- J Doughari, AM Elmahmood and S Manzara. African J Microbiol Res. 2007,1(3): p. 037-041.